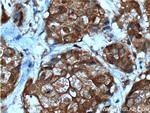
NMD3 Antibody in Immunohistochemistry (Paraffin) (IHC (P))

Search
Proteintech
NMD3 Polyclonal Antibody
{{$productOrderCtrl.translations['antibody.pdp.commerceCard.promotion.promotions']}}
{{$productOrderCtrl.translations['antibody.pdp.commerceCard.promotion.viewpromo']}}
{{$productOrderCtrl.translations['antibody.pdp.commerceCard.promotion.promocode']}}: {{promo.promoCode}} {{promo.promoTitle}} {{promo.promoDescription}}. {{$productOrderCtrl.translations['antibody.pdp.commerceCard.promotion.learnmore']}}
产品信息
16060-1-AP
种属反应
已发表种属
宿主/亚型
分类
类型
抗原
偶联物
形式
浓度
规格
纯化类型
保存液
内含物
保存条件
运输条件
产品详细信息
Immunogen sequence: KAVIQVRQK TLHKKTFYYL EQLILKYGMH QNTLRIKEIH DGLDFYYSSK QHAQKMVEFL QCTVPCRYKA SQRLISQDIH SNTYNYKSTF SVEIVPICKD NVVCLSPKLA QSLGNMNQIC VCIRVTSAIH LIDPNTLQVA DIDGSTFWSH PFNSLCHPKQ LEEFIVMECS IVQDIKRAAG AGMISKKHTL GEVWVQKTSE MNTDKQYFCR THLGHLLNPG DLVLGFDLAN CNLNDEHVNK MNSDRVPDVV LIKKSYDRTK RQRRRNWKLK ELARERENMD TDDERQYQDF LEDLEEDEAI RKNVNIYRDS AIPVESDTDD EGAPRISLAE MLEDLHISQD ATGEEGASML T (154-503 aa encoded by BC013317)
靶标信息
NMD3 is a cytoplasmic factor required for a late cytoplasmic assembly step of the 60S subunit but is not a ribosomal protein. A mutation in NMD3 was found to be lethal in the absence of XRN1, which encodes the major cytoplasmic exoribonuclease responsible for mRNA turnover. The NMD3 protein sequence does not contain readily recognizable motifs of known function. However, NMD3 orthologues display an amino-terminal domain containing four repeats of Cx2C, reminiscent of zinc-binding proteins, implicated in nucleic acid binding or protein oligomerization.
仅用于科研。不用于诊断过程。未经明确授权不得转售。
生物信息学
蛋白别名: 60S ribosomal export protein NMD3; hNMD3; NMD3 homolog; unnamed protein product
基因别名: C87860; CGI-07; NMD3; RGD1308468
UniProt ID: (Human) Q96D46, (Mouse) Q99L48
Entrez Gene ID: (Human) 51068, (Mouse) 97112, (Rat) 310512